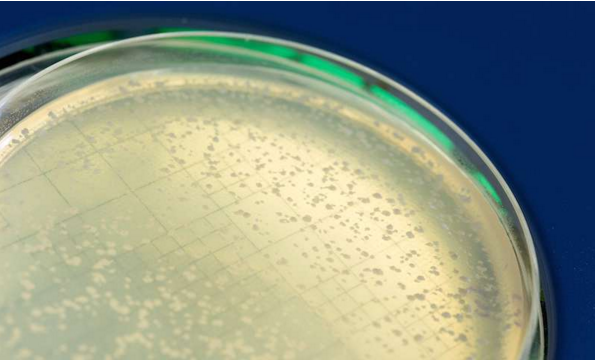

新闻资讯
本专题为癌症123的癌症专题,内容全部来自癌症123精心选择与癌症相关的最近资讯,癌症123读懂智能与未来,拥有癌症资讯的信息,在这里你能看到未来的世界。
*以上解读内容仅供参考,癌症123不对解读内容负责。
辉瑞肺癌新药获首项积极 3 期临床成果
2017-06-09今日的 ASCO 年会上,辉瑞(Pfizer)宣布其在研肺癌新药 dacomitinib 在一项 3 期临床试验中表现出色。与标准疗法相比,这款...
又一个“广谱抗癌药”Larotrectinib,治疗各种成人及儿童癌症疗效持久
2017-06-09在日前召开的美国临床肿瘤学会(ASCO)会议上,纪念斯隆 - 凯特琳癌症中心的 David Hyman 博士公布了由 Loxo Oncology 公司...
和黄癌症新药 3 期成功 将在中国申请上市
2017-06-09近日,药明康德合作伙伴公司 Hutchison China MediTech(Chi-Med,和黄中国医药科技)在美国临床肿瘤学会(ASCO)年会上以口头报...
吞胶囊验“粑粑”查肠癌
2017-06-09王磊高翔肠道息肉在人群中的发病率不低。从肠道出现病变到进展为癌症,通常会有十年左右的时间,该如何拦截癌变?你可能无法想象:吞一颗...
血液检测技术明星公司“圣杯”投资 10 亿美元,押注早期癌症检测
2017-06-0970% 在早期被发现的癌症能够治愈。我们能否通过血液检查及时发现?位于南卡罗莱纳州斯帕坦堡(Spartanburg)的吉布斯癌症中...
Tucatinib 治疗脑转移乳腺癌获 FDA 孤儿药认定
2017-06-096 月 8 日,美国临床阶段生物制药公司 Cascadian Therapeutics 表示,公司在研 HER2 高选择性口服小分子激酶抑制剂 Tucat...
科学家找到受损 DNA 修复“关键”,抗癌新方法有望问世!
2017-06-09德雷塞尔大学和佐治亚理工学院的研究人员发现,Rad52 蛋白质是 DNA 修复的关键所在。最新的研究发表结果发表于《分子细...
维生素 D 可减缓结直肠癌的恶化
2017-06-09近年来,研究数据表明,维生素 D 在血浆中的含量越高,越能提高结直肠癌患者的生存率。如今,首次随机实验证明,高剂量补充维生素 D 可有效减缓疾病的恶化。该...
遗传性BRCA乳腺癌新希望 新靶向药即将来临
2017-06-09近日,研究人员发现了一种可能用于年轻女性遗传难治性乳腺癌的新型靶向疗法。 密歇根大学科学家在世界最大癌症会议ASCO上发表公布了他们的最新研究结果,一项小型研究...
Tucatinib治疗脑转移乳腺癌获FDA孤儿药认定
2017-06-096月8日,美国临床阶段生物制药公司Cascadian Therapeutics表示,公司在研HER2高选择性口服小分子激酶抑制剂Tucatinib已被美国FDA授予治疗具有脑转移乳腺癌的孤儿药...
这样竟然提高癌细胞的生存率和耐药性
2017-06-09来自加利福尼亚大学圣地亚哥分校医学院的研究人员报告说,癌细胞似乎能够与其他癌细胞进行通讯,激活一种内部机制从而增强对化疗的耐药性并提高肿瘤生存能力。 这一研...
3.7 亿!诺和诺德肿瘤候选药卖给 Innate 制药
2017-06-09近日,Innate 制药与诺和诺德签署了新的合作协议,购买了旗下新的肿瘤免疫候选药物。 Innate 制药将获得诺和诺德首款类临床阶段抗 -C5aR 抗体(IPH5401)的全...
下一代癌症药物可以增强免疫治疗反应
2017-06-09在早期临床试验中,一种释放抗癌免疫反应的方法显示出疗效,并可能提高现有疗法的有效性。 IDO 蛋白质作为实验靶向药物,其通过分解关键的氨基酸 - 色氨酸...
未来 5 年最畅销的抗肿瘤药物
2017-06-09据《美国医学会杂志》报道,2013 年全球癌症患者约为 1540 万。其中,发展中国家的癌症死亡率高于发达国家,患病人数占到全球的 57%,死亡人数高达全球的 65%。2013 年中国癌症发病...
改装 T 细胞,治疗癌症更有效
2017-06-09科学家们用一种新的表面分子来武装免疫细胞。这使得免疫细胞在遇到肿瘤实际上用来伪装自己逃避免疫系统的一种蛋白质时,反应特别强烈。来自亥姆霍兹慕...
科学家提供癌性骨痛的解决策略,给癌症患者带来福音!
2017-06-09圣路易斯大学研究员 Daniela Salvemini 博士发表的一篇文章报告发现了一种推动癌症相关骨痛的关键分子途径,同时提供了已经在市场上销售的药物的潜在...
有效率 100%,中国 CAR- T 癌症免疫治疗团队成 ASCO 最闪亮的新星
2017-06-08目前,癌症治疗中,化疗反应率大约是 10%-30%,免疫系统药物最高的反应率在 35%-40%,即便是靶向药物,反应率也就是 70%-80%。然而在芝加哥举行的美国临床肿瘤...
突破:癌症或可早期经抽血得以发现!
2017-06-08在对 124 位晚期乳腺癌,肺癌和前列腺癌患者的研究中,一种新的高强度基因组测序方法以高比率检测了循环肿瘤 DNA。在 89%的患者中,其血液中也检测到至少...
癌细胞结成“联盟”是癌症难以攻克的重要原因!
2017-06-08加利福尼亚大学圣地亚哥分校医学院的研究人员报告说,癌细胞似乎与其他癌细胞通信,激活内部机制,增强对常见化学疗法的抵抗力,促进肿瘤的存活。 研究结果...
新药 enasidenib:有效控制和缓解致命癌症
2017-06-08根据今日发表于《美国血液学会杂志》上的文章表示,一种实验室靶向疗法对复发性或难治的血液癌症—急性髓系白血病(AML)提供了全新的治疗方法。多达 15%...
科学家通过控制这些“开关”给癌细胞致命一击!
2017-06-08瑞典 Karolinska Institutet 的科学家报告说,癌细胞和正常细胞使用不同的“基因开关”来调节控制生长的基因的表达。在小鼠中,去除与不同类型癌症相关...
肺癌靶向药现有慈善援助项目汇总
2017-06-07目前共有5个慈善项目,对应药品分别是: 易瑞沙(吉非替尼), 特罗凯(尼洛替尼), 赛可瑞(克唑替尼), 凯美纳(盐酸埃克替尼), 安维汀(贝伐珠单抗)。 中华慈善总会【易瑞沙】慈善援助项目 项目...
Nivolumab与Ipilimumab联合治疗结直肠癌患者获得积极的研究结果
2017-06-07(2017年6月3日,美国新泽西州普林斯顿) - 百时美施贵宝公司(纽约证交所代码:BMY)宣布了一项名为CheckMate-142的II期多队列临床研究的中期数据,该研究评估了nivolumab单...
「乐伐替尼」肝癌数据强势亮相!索拉非尼一线地位遭挑战
2017-06-07卫材今年2月曾宣布,在一项以索拉非尼为对照的一线治疗晚期肝细胞癌III期研究(Study 304)中,乐伐替尼治疗组的总生存期不劣于索拉非尼(sorafenib),到达了非劣效终点。虽然当...
Keytruda胃癌:应答率11.6% PD-L1阳性患者效果更好
2017-06-07默沙东6月4日在ASCO2017大会上公布了PD-1单抗Keytruda治疗晚期胃癌患者的KEYNOTE-059研究队列1的数据。 KEYNOTE-059是一项多队列、非随机、II期研究。队列1入组的...